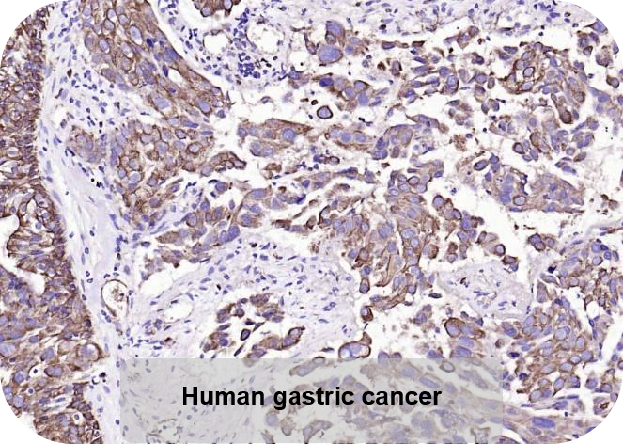
新闻图片4

10 年
手机商铺
公司新闻/正文
429 人阅读发布时间:2021-12-24 09:27

Cytokeratin19(CK19)是角蛋白家族的一员。角蛋白是负责上皮细胞结构完整性的中间丝蛋白,又分为细胞角蛋白和毛发角蛋白。细胞角蛋白的分子量为 40-68 KDa,等电点 pH 在 4.9 - 7.8 之间。人体内的各种上皮细胞通常表达细胞角蛋白,这些细胞角蛋白不仅在类型上有所不同,而且也与上皮细胞的成熟或分化程度有关。细胞角蛋白亚型的表达模式也被用于区分不同类型的上皮恶性肿瘤。
Anti-Cytokeratin 19 细胞角蛋白 19 单克隆抗体
IHC验证数据图:

Anti-CK17 细胞角蛋白 17 单克隆抗体
IHC验证数据图:






Bioss三大产品优势
品种多样,特异性好,批次稳定
1000 多种目录产品
为什么选择Bioss?
Bioss自成立之日起,20年来一直致力于科研抗体的研发、生产、销售,已研发出14000+靶点在线抗体,特色产品如特异磷酸化抗体及29种不同标记物如PE、APC、PerCP、Cy3、Cy5、Cy7、AF647、AF488、AF555、AF495等标记的直标抗体。此外,公司还提供完善的单/多克隆抗体制备、标记、重组蛋白、多肽合成及各项免疫学检测技术服务等,为您的免疫学相关实验提供一站式服务。